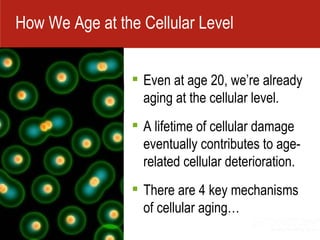
Even at age 20, we’re already aging at the cellular level. A lifetime of cellular damage eventually contributes to age-related cellular deterioration.   There are 4 key mechanisms of cellular aging… How We Age at the Cellular Level

The document describes a supplement product called Vivix that is claimed to be a revolutionary breakthrough in cellular anti-aging. It discusses four key mechanisms of cellular aging and how Vivix ingredients have been shown in laboratory studies to positively impact these mechanisms by protecting and repairing DNA, promoting mitochondrial biogenesis, slowing the accumulation of AGE proteins, and positively impacting genetic regulators. Vivix is described as the most complex product ever created by Shaklee using a rare super grape and proprietary extraction process to produce a potent anti-aging formula.